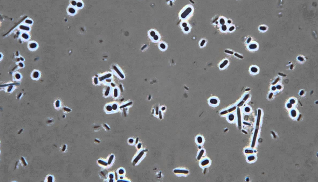

how does a light microscope work and what is it used for
uses light and a magnifying lens to view small objects

how does a digital microscope work
uses optics and a digital camera to output an image to a monitor

how does a fluorescence microscope work
uses fluorescence to generate an image
used in conjunction with a flourescently stained organism which will produce a color when exposed to a wavelength of light

how does a phase contrast microscope work
light is shone through a transparent specimen
phase shifts are converted to brightness changes in the image
how does a dark field microscope work
light it shone at a specimen and produces a dark area around the specimen
this darkness occurs because there is nothing in those areas to scatter the beam of light

how does an electron microscope work
uses a beam of accelerated electrons as a source of illumination

what are the some phenotypic ways to classify an organism
size
shape
hemolysis
texture
rate of growth
color
odor
what is the difference between genotype and phenotype
genotype: unique, genetic DNA
phenotype: observable expression (ex. size)
what are the two modes of transmission of diseases
direct and indirect
what are 5 examples of direct transmission of disease
1.) direct contact
2.) droplet infection
3.) contact with soil
4.) inoculation into skin or mucosa (vaccines)
5.) transplancental (vertical)
what are 5 examples of indirect transmission of disease
1.) vehicle (water, food, air, and medical devices)
2.) vector (animals, insects, and other humans)
3.) air
4.) fomite (objects likely to carry infection like furniture)
5.) unclean hands and fingers
what are the two intervening agents for modes of transmission
vectors and vehicles
what makes up the specific immune response
memory through previous exposures (vaccines)
how does the ingestion and removal process of invaders work
phagocytes ingest the bacteria by endocytosis
they engulf in phagosomes which then fuse with lysosomes
toxic chemicals in the lysosomes destroy the invaders
which antibody is the most abundant antibody produced
IgG
which antibody is the largest in size and is the initial antibody produced in reaction to an infection
IgM
which antibody is found in various body fluids
IgA
which antibody is secreted in parasitic infections and during allergies
IgE
which antibody is attached to the surface of specific immune system cells and is involved in the regulation of antibody production
IgG
generally, how does antibody-mediated immunity work
B-cells are stimulated by helper T-cells to become plasma cells and memory B-cells
plasma cells make antibodies
generally, how does cell-mediated immunity work
helper T-cells stimulate cytotoxic T cells
memory T-cells are created
what are virulence factors
characteristics of organisms allow them to cause disease in humans
what are the 5 main virulence factors
1.) ability to attach
2.) ability to invade
3.) ability to survive inflammation
4.) ability to survive against the immune system
5.) production of microbial toxins
what are the three methods of accomplishing diversity in bacteria
1.) mutation
2.) genetic recombination
3.) gene exchange




